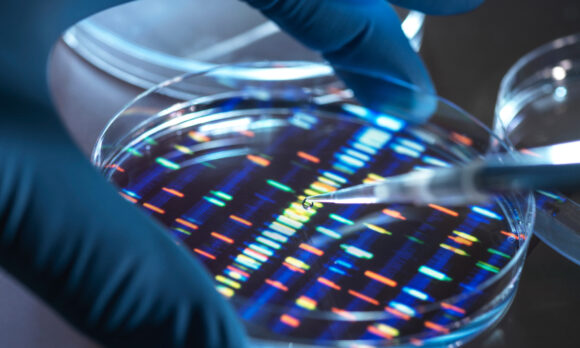

February 08, 2023
Sharper: Critical Technology
Analysis from CNAS experts on the most critical challenges for U.S. foreign policy.
By:Anna PedersonandSam Howell
Critical technologies promise to upend traditional understandings of national security, economic prosperity, and everyday life. Artificial intelligence, semiconductors, quantum information technologies, biotechnologies, and related technology areas are applicable to a range of industries, from defense and logistics to agriculture and medicine. These technologies, which afford nation-states new tools and vulnerabilities, have become a crux of U.S.-China competition, and a prominent part of cooperation and contention with allies and partners. CNAS experts are sharpening the conversation around the policy challenges associated with critical technologies and how the United States can maintain its technological superiority in the digital age. Continue reading this edition of Sharper to explore their ideas and recommendations.
Features
DoD Autonomous Weapons Policy
In January, the U.S. Defense Department (DoD) released an updated version of its policy on autonomous weapons, DoD Directive 3000.09, Autonomy in Weapon Systems. This was the first major policy update since 2012. In this CNASNoteworthy, Vice President and Director of Studies Paul Scharre breaks down the new Directive and what it means for the U.S. military’s approach to lethal autonomous weapon systems. Dr. Scharre led the DoD working group that drafted the original DoD directive 3000.09 in 2012.
Networked: Techno-Democratic Statecraft for Australia and the Quad
A strategic competition is underway—and technology stands at its core. Technology-leading countries will drive the digital economy, gain political power and military strength, and shape global norms for technology use. In a CNAS report, author Martijn Rasser lays out a blueprint for techno-democratic statecraft in the Quad. Thisreport examines the technologies propelling rapid change, the competing visions for technology use driving geopolitical strains, and the opportunities and challenges posed by Quad members' approaches to technology.
Myths and Realities of China’s Military-Civil Fusion Strategy
Beijing’s drive to create stronger linkages between its civilian economy and defense industrial base has started to draw considerable attention in Washington. In a CNASreport, experts Elsa B. Kania and Lorand Laskai dispel four prominent myths about China’s efforts in military-civil fusion (MCF). Their report seeks to improve policymakers’ understanding of the challenges MCF presents while enhancing the U.S. government’s ability to grapple with these issues.
NOTEWORTHY: DoD Autonomous Weapons Policy
In this CNAS Noteworthy, Vice President and Director of Studies Paul Scharre breaks down the new Directive and what it means for the U.S. military’s approach to lethal autonom...
Networked: Techno-Democratic Statecraft for Australia and the Quad
Australia is well positioned to lead the Quad to achieve important technology policy objectives....
Myths and Realities of China’s Military-Civil Fusion Strategy
In U.S. policy debates on China, military-civil fusion (MCF) has emerged as a frequent subject of debate and concern....
CNAS Biotech Task Force Issues Statement of Purpose
Biotechnology is primed to transform global society and the geopolitical landscape. Breakthroughs in areas including synthetic biology and genomic editing, next generation pharmaceuticals, and bioinformatics are already revolutionizing how we build and manufacture, treat and prevent illness, grow food, generate and store energy, and tackle existential threats from pandemics to climate change. Some advances have the potential to open new domains and capabilities in warfare, such as human performance enhancement and medical care, or for misuse by adversaries, such as with biological weapons. Established in November 2022, the CNAS Biotech Task Forcedevelops pragmatic policy recommendations to address acute biosecurity challenges such as bioterrorism and bolster American competitiveness across the biotechnology landscape.
Sand in the Silicon: Designing an Outbound Investment Controls Mechanism
While broad outbound investment screening authorities were ultimately dropped from the CHIPS and Science Act, the debate over outbound investment is far from over. The concept of outbound investment controls has gained bipartisan support in Congress and the administration has also endorsed the idea. New authorities with new powers are likely in the coming year, but significantchallenges remain in designing an outbound investment mechanism. The Energy, Economics, and Security Program at the Center for a New American Security and the Atlantic Council GeoEconomics Center have joined together to develop pragmatic recommendations for designing workable outbound investment screening authorities.
A Conversation with Under Secretary of Commerce Alan F. Estevez
The U.S. Department of Commerce Bureau of Industry and Security issued a rule that imposes significant new export controls designed to limit the development, purchase, production, and use of semiconductors, semiconductor manufacturing equipment, and supercomputers in China. To discuss the rationale behind and the scope, scale, and implementation of these new controls, CNAShosted Alan F. Estevez, Under Secretary of Commerce for Industry and Security, for a moderated discussion and a question and answer session with Martijn Rasser, Senior Fellow and Director of the Technology and National Security program.
CNAS Biotech Task Force Issues Statement of Purpose
For more information or to schedule an interview, please contact Cameron Edinburgh at[email protected]....
Sand in the silicon: Designing an outbound investment controls mechanism
Recent congressional efforts to establish new authorities to regulate outbound investment have revived a long-simmering debate in Washington about the economic and security ri...
Special Event | A Conversation with Under Secretary of Commerce Alan F. Estevez
Martijn Rasser
Oct 27, 2022
Commentaries
How to Stop the Next World War
"Our efforts to help restore the technological prowess of the U.S. military started six years ago in a Pentagon conference room,"write Robert O. Work and Eric Schmidt inThe Atlantic. "One of us, a former executive and tech innovator in Silicon Valley, was then serving as the head of the Defense Innovation Board, created to match the needs of the Department of Defense with America’s most advanced technologies. The other was the deputy secretary of defense, reworking the U.S. military’s strategy for the growing competition among the world’s great powers. Though we’d never met before, we quickly realized we had reached the same conclusion: In failing to adapt to the changing character of warfare and great-power competition, America risked setting itself up for a catastrophic defeat."
How to Win Friends and Choke China’s Chip Supply
"Washington should proactively work with partners to mitigate the economic effects of the new controls, providing clarity and predictability for industry participants with investment timelines that stretch over a decade,"argues Emily Kilcrease inWar on the Rocks. "Guidance on future licensing policy, as well as exemptions from the extraterritorial aspects of the new rules for those countries that implement substantially similar controls, should feature prominently in the ongoing negotiations. The ultimate objective should not be to have all partners implement identical controls. Instead, U.S. officials should prioritize aligning controls with other major producer nations to target the most significant technology chokepoints and the areas where the risk of backfilling U.S. technologies is highest."
The China-U.S. Quantum Race
"Quantum researchers in China claim to have an algorithm capable of breaking public-key encryption, years before anyone expected,"writes Sam Howell inThe Diplomat. "Accurate or not, the announcement serves as a reminder that surprising quantum breakthroughs are possible in the near term. If the Biden administration is serious about its designation of quantum information science (QIS) as a critical technology area for national security, it must do more to safeguard U.S. quantum superiority."
How to Stop the Next World War
Russia’s invasion of Ukraine has given us a glimpse of what the return of industrial-scale warfare would mean....
How to Win Friends and Choke China’s Chip Supply
U.S. officials should prioritize aligning controls with other major producer nations to target the most significant technology chokepoints and the areas where the risk of back...
The China-US Quantum Race
The country leading in quantum will be able to threaten adversaries’ corporate, military, and government information infrastructure faster than an adversary can implement effe...
In the News
Featuring commentary and analysis from Martijn Rasser, Lisa Curtis, Becca Wasser, Sam Howell, and Jennifer McArdle.
America’s Hoped-For Asian Semiconductor Pact Looks Tricky
The vision of a “democratic semiconductor supply chain” is not implausible. But creating chip networks rather than fuelling chip wars will require careful co-ordination within...
India, US Are Ready to Break Down Barriers to Closer Technology and Defence Cooperation: Experts
Announced during US President Joe Biden and Prime Minister Narendra Modi’s bilateral talks in Tokyo in May last year, the iCET is spearheaded by the National Security Councils...
White House Optimistic on Tech Sharing for AUKUS Security Pact
Becca Wasser, a defence expert at the CNAS think-tank, said there was a push to make progress on the tech transfer issue but cautioned that wholesale reform of Itar would be h...
Huawei Latest Target of US Crackdown on China Tech
Since taking office in 2021, President Joe Biden has taken an even more aggressive stance than his predecessor, Donald Trump. Now the Biden administration appears to be headin...
Into the Military Metaverse: An empty buzzword or a virtual resource for the Pentagon?
Years before the word “metaverse” existed, the Pentagon was experimenting with the broad concept of interconnected virtual worlds. In 1978, Air Force Capt. Jack Thorpe publish...
Thank you for registering! You will receive a confirmation email shortly. All CNAS events are free, open to the public, and viewable fromcnas.org/live.
Stay up-to-date with report releases, events, major updates, and announcements from the Center for a New American Security.
More from CNAS
Technology & National Security
Prepared, Not ParalyzedExecutive SummaryThe Trump administration has embraced a pro-innovation approach to artificial intelligence (AI) policy. Its AI Action Plan, released July 2025, underscores t...
By Janet Egan, Spencer Michaels & Caleb Withers
- November 20, 2025
Indo-Pacific Security /Technology & National Security
Sharper: Tech + ChinaRecent talks between President Donald Trump and Chinese Communist Party General Secretary Xi Jinping placed a spotlight on emerging technologies, from high-end chips to minera...
By Charles Horn & Sevi Silvia
- November 19, 2025
- The Real Impact of SCOTUS's Tariff Hearing with Kathleen Claussen
Kathleen Claussen, Professor of Law at Georgetown University, joins Emily and Geoff to discuss the SCOTUS case on Trump's tariffs. They share their insights from the recent SC...
By Emily Kilcrease & Geoffrey Gertz
- November 13, 2025
- The Future of IEEPA Tariffs with Geoffrey Gertz
On November 5, the Supreme Court of the United States heard oral argument on the use of the International Emergency Economic Powers Act (IEEPA) by President Donald Trump to im...
By Geoffrey Gertz
- November 11, 2025